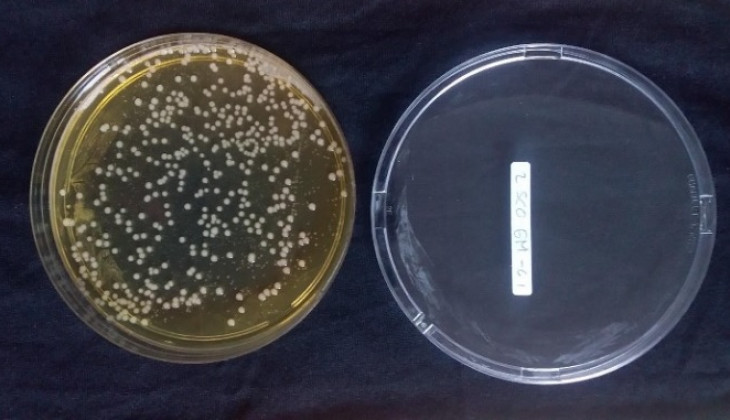
Mahasiswa UGM Kembangkan Medium Pertumbuhan Bakteri Asam Laktat Berbahan Baku Limbah Organik Pasar

Schoolmedia News Jakarta ---- Provinsi Jawa Tengah berhasil meraih juara umum Festival dan Lomba Seni Siswa Nasional (FLS2N) tahun 2021, dengan raihan 9 medali emas, 5 medali perak dan 4 medali perunggu. Menteri Pendidikan, Kebudayaan, Riset, dan Teknologi (Mendikbudristek), Nadiem Anwar Makarim, memberikan apresiasi serta penghargaan kepada para peraih juara ajang bergengsi tingkat nasional tersebut.
“Pada hari ini, kita semua berbangga, generasi-generasi hebat di bidang seni, telah lahir. Namun, kompetisi dan medali bukan segala-galanya, karena sang juara yang sesunguhnya adalah adik-adik semua, pelajar yang penuh integritas, talenta muda yang akan membawa Indonesia ke panggung dunia,” ujar Menteri Nadiem dalam arahan sekaligus menutup FLS2N tahun 2021, secara daring.
Di tengah situasi pandemi Covid-19 dan era disrupsi, kata Menteri Nadiem kompetisi seperti ini memaksa masyarakat untuk melakukan perubahan yang semakin cepat di berbagai bidang pendidikan, industri teknologi, maupun budaya. Untuk itu, Pemerintah Indonesia mendorong terciptanya sumber daya manusia (SDM) unggul, pemimpin masa depan Indonesia yang gemilang. “Apa yang kita lakukan melalui kegiatan kompetisi, lomba, dan festival ini, adalah salah satu bukti bahwa kita dapat beradaptasi dan melakukan transformasi dalam belajar dan berprestasi,” tegasnya.
Dalam penutupan FLS2N 2021, ditetapkan 60 siswa peraih medali emas, 40 siswa peraih medali perak, dan 40 siswa peraih medali perunggu yang berasal dari berbagai sekolah jenjang pendidikan dasar dan menengah dari 34 provinsi, serta 7 Sekolah Indonesia di Luar Negeri (SILN). “Kemenangan kalian adalah prestasi kita semua. Saya ucapkan selamat kepada para peraih medali,” tutur Menteri Nadiem.
Dalam pelaksanaan FLS2N 2021, hasil karya/penampilan tahap akhir yang dinilai oleh panitia menunjukkan kenaikan dibanding tahun sebelumnya, dengan total 1.220 karya/penampilan yang dihasilkan oleh 1.883 siswa yang dinilai oleh tim juri pada jenjang SD terdapat lima jenis kesenian yang dilombakan, antara lain seni tari, menyanyi tunggal, kriya anyam, gambar bercerita, dan pantomim yang diikuti oleh 256 siswa dengan jumlah 160 karya.
Pada jenjang SMP, ada lima lomba kreativitas tari, lomba menyanyi solo, gitar duet, musik tradisional, dan desain poster yang diikuti oleh 467 siswa dengan 167 karya yang sudah terdaftar. Pada jenjang SMA, peserta yang terdaftar sebanyak 414 siswa dengan 369 karya yang terdiri dari 11 lomba seni yaitu baca puisi, cipta lagu, desain poster, film pendek, gitar solo, komik digital, kriya, monolog, tari kreasi, vokal solo putra, dan vokal solo putri.
Sementara itu, peserta SMK yang terdaftar sebanyak 405 siswa dengan 281 karya yang sudah masuk ke panitia dengan delapan lomba seni diantaranya menyanyi solo, gitar solo, film pendek, monolog, tari tradisional, musik tradisi daerah, cipta lagu, dan seni lukis.
Pada pendidikan khusus, untuk SD Luar Biasa (LB) ada lomba menyanyi dan melukis. Untuk SMPLB dan SMALB ada lomba cipta baca puisi, cipta komik strip, desain grafis, melukis, menari, menyanyi, Musabaqah Tilawatil Qur’an (MTQ), dan pantomim. Jumlah peserta yang terdaftar sebanyak 341 siswa dengan 243 karya.
Pada kesempatan yang sama, pelaku seni pantomim yang menjadi juri lomba pantomim jenjang SD, Septian Dwi Cahyo mengungkapkan kegembiraannya atas tetap diselenggarakannya FLS2N meski di tengah suasana pandemi. “Peserta didik tetap harus disediakan wadah untuk mengasah minat dan bakatnya. Terutama dengan melihat potensi besar yang dimiliki siswa di bidang seni dengan terlihat dari meningkatnya hasil karya yang dinilai oleh juri dalam lomba tahun ini. Apresiasi untuk Puspresnas yang tetap menggelar FLS2N meski secara daring,” tutupnya.
Dukungan serta apresiasi atas terselenggaranya FLS2N tahun 2021 juga disampaikan oleh berbagai pemangku kepentingan yakni Ketua Komisi X DPR RI, Syaiful Huda, Staf Khusus Kantor Staf Presiden (KSP) Bidang Manajemen Talenta Nasional, Avanti Fontana, serta Direktur Jenderal Pendidikan Anak Usia Dini, Pendidikan Dasar, dan Pendidikan Menengah Kemendikbudristek, Jumeri.
Melalui tema yang diusung FLS2N tahun 2021 yakni “Seni Pulihkan Negeri”, Kemendikbudristek hendak merefleksikan semangat tanpa lelah para peserta didik untuk terus berjuang dan terus berdiri tegak menghadapai Covid-19 dengan berkesenian. Untuk memerihkan acara penutupan, panitia pelaksana menampilkan hiburan tari dan menyanyi solo dari alumni FLS2N, serta penampilan duet kolaborasi lagu inspiratif dengan judul lagu “Pulihkan Negeri”.
Penulis Tim Schoolmedia

Tinggalkan Komentar